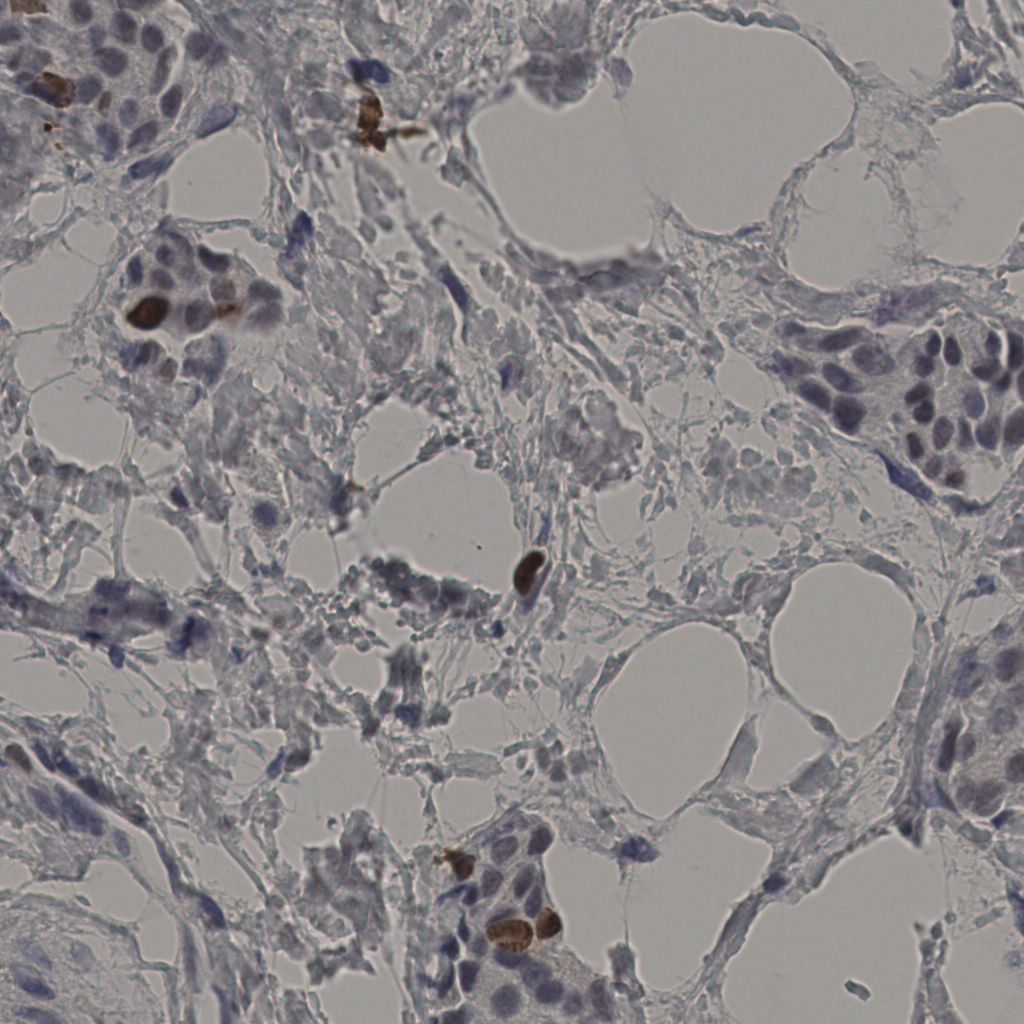
slice_38_14_x34048_y12544.png

5.31%
Ki67 指数
阴 19502
阳 1093
处理信息
状态
处理完成
上传
2026-04-09 16:49
耗时
4998秒
切片统计
总切片
2970
有效
554
已标记
554
有效率
19%

slice_37_8_x33152...

slice_37_9_x33152...

slice_38_10_x3404...

slice_38_11_x3404...

slice_38_12_x3404...

slice_38_13_x3404...
slice_38_14_x3404...

slice_38_15_x3404...

slice_38_16_x3404...

slice_38_17_x3404...

slice_38_18_x3404...

slice_38_22_x3404...

slice_38_23_x3404...

slice_38_24_x3404...

slice_38_25_x3404...

slice_38_26_x3404...

slice_38_28_x3404...

slice_38_29_x3404...

slice_38_30_x3404...

slice_38_31_x3404...
